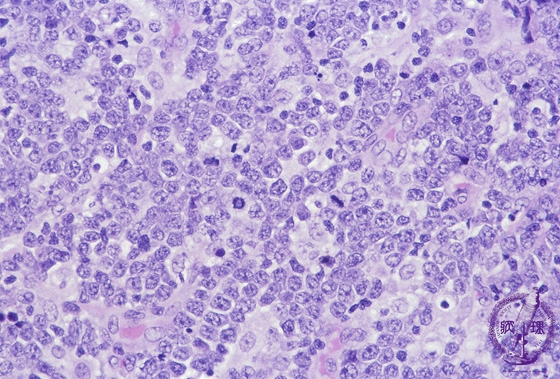

- 2.Lymph node
- (7)Burkitt lymphoma
Microscopic image (H&E high power view): There is a diffuse proliferation comprised of small blast cells which contain scant cytoplasm and frequently display mitotic figures. Burkitt lymphoma primarily affects children and young adults. An association with EB virus (Epstein-Barr virus: EBV) is documented. Abnormally increased c-Myc gene expression is due to chromosomal translocation [t(8;14)].
Click the image to see the enlarged image.









